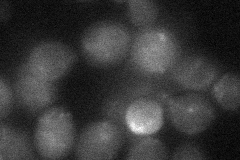
YDR004W
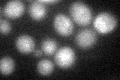
YDR004W

View description
Protein that stimulates strand exchange by stabilizing the binding of Rad51p to single-stranded DNA; involved in the recombinational repair of double-strand breaks in DNA during vegetative growth and meiosis; forms heterodimer with Rad55p
Localization:
Intensity:
Fold change:
Significance:
-
C’ GFP library in SD

nucleus:cytosol17.24 -
N' NOP1pr-GFP in SD

nucleus48.7985 -
N' TEF2pr-mCherry in SD

nucleus18.9081 -
N' NATIVEpr-GFP in SD

below threshold18.9391 -
N' TEF2pr-VC and Cyto-VN in SD
below threshold24.664 -
C’ GFP library in SD+DTT
nucleus.cytosol19.11.1No -
C’ GFP library in SD+H2O2

nucleus.cytosol19.211.11No -
C’ GFP library in Starvation Media

nucleus,cytosol14.750.85No -
C’ GFP library on the background of Pup2-DaMP

nucleus:cytosol -
C’ GFP library on the background of CCT mutant

nucleus:cytosol20.321.17802No
